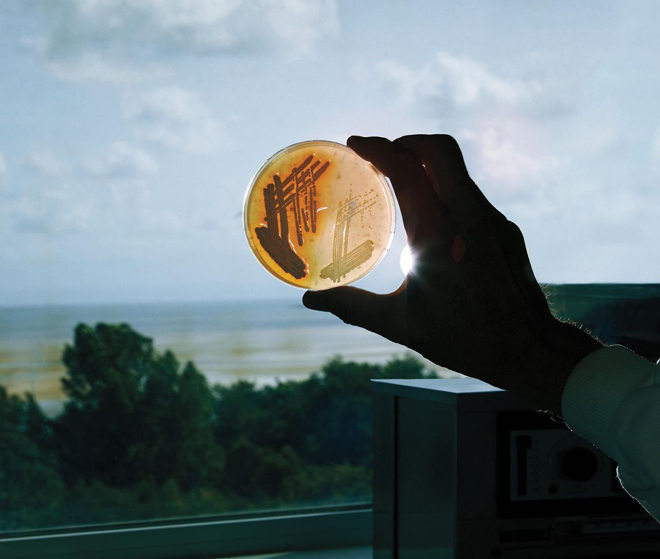

Kỳ bí huyệt mộ chữa bệnh tại Bắc Ireland
Giải mã ngôi mộ chữa bệnh
Đó là một ngày tuyệt vời để dạo quanh nghĩa địa: một chốn ẩm thấp, tối tăm và cấm đoán. Một màn sương mỏng giăng ngay cổng vào Nhà thờ Công giáo La Mã Thánh Tâm, sương ẩm rỉ ra như nước mắt người than khóc. Trong ngôi nhà thờ Bắc Ireland này, các thửa đất an táng nằm theo từng dãy dài cho người quá cố.
![]() |
| Du khách tìm ngôi mộ của linh mục James McGirr. Ảnh nguồn: Simon Watson. |
Tôi (tác giả Franz Lidz) vượt qua Cây thập giá Boho High của Hạt Fermanagh (một tượng đài được dựng từ thế kỷ thứ 10, có khắc những hình họa mô tả lễ Rửa tội Chúa Hài Đồng) và đứng trước tấm bia đá của ngôi mộ James McGirr, một cha xứ đã qua đời từ năm 1815, thọ 70 tuổi.
Ngay tại cao nguyên Boho, một phần của phía Tây Fermanagh (cách đó 5 dặm là biên giới nước Cộng hòa Ireland), nơi đây trong suốt nhiều thế kỷ các giáo dân đã mặc nhiên tin rằng huyệt đất chôn Cha xứ McGirr có chứa những quyền năng chữa bệnh kỳ diệu.
Ông Gerry Quinn, một nhà vi trùng học lớn lên trong vùng, giải thích: “Cha McGirr nhân từ cũng được tin là một thầy lang mát tay. Ngay trên giường bệnh trong phút lâm chung, cha McGirr nhắn gửi người thân: “Sau khi tôi đi, đất sét bao quanh da thịt tôi sẽ chữa được mọi thứ y như cách tôi đã trị khỏi bệnh lúc sinh thời”. Chính lời trăng trối này đã hình thành một thứ phong tục dị thường của người dân địa phương: những bệnh nhân sẽ quỳ mọp bên mộ McGirr, họ bóc ra một mẫu đất và cho nó vào một cái túi bông.
Ông Gerry Quinn nhấn mạnh: “Lấy được mẫu đất, các bệnh nhân sẽ mang nó về nhà (họ nhịn đau và không hé môi nói với bất kỳ ai lúc đi đường) và đặt cái túi bông dưới gối nằm. Mẩu đất được tin là sẽ chữa khỏi những căn bệnh nhẹ như sưng vết thương và viêm họng”. Vào những buổi chiều nhất định, trên mặt đất nghĩa địa đã thấy la liệt các loại muỗng của bệnh nhân bỏ lại.
![]() |
| Ông Gerry Quinn (Đại học Ulster, Bắc Ireland) so sánh việc thu hoạch xạ khuẩn với trồng phong lan “cần thời gian và kiên nhẫn”. Ảnh nguồn: Simon Watson. |
Trên tấm bia mộ của vị cha xứ quá cố có đề hàng chữ mà người đến viếng bắt buộc phải tuân thủ: Chỉ xúc 1 muỗng đất mang đi và phải trả lại cho mộ cha McGrirr vào ngày thứ 4”. Nhà vi trùng học Gerry Quinn lý giải: “Theo truyền thuyết, bất kỳ ai cố tình lấy đất từ mộ cha McGirr mà không trả lại chỗ cũ sẽ chuốc lấy xui xẻo”.
Với những người không tin chuyện hoang đường, có lẽ liều thuốc kỳ diệu ở nghĩa địa Hạt Fermanagh hẳn sẽ đọng lại sự hoài nghi. Song, các truyền thuyết ít nhiều sẽ có một số sự thật. Ông Gerry Quinn (người đã chuyển đến Đại học Ulster (Bắc Ireland) và các đồng nghiệp của ông tại trường y của Đại học Swansea (xứ Wales) đã khám phá ra rằng loại bụi đất Boho (đọc là Bo) có chứa các đặc tính kháng sinh độc đáo và nó cung cấp một loại vũ khí mới trong cuộc chạy đua dài hạn nhằm chống lại các vi khuẩn kháng kháng sinh.
Theo các nhà nghiên cứu của Đại học Swansea, lớp đất phủ lên thân xác Cha McGirr có chứa một chủng xạ khuẩn (Streptomyces) chưa từng được biết đến, và nó đã sản xuất ra khoảng 2/3 của tất cả các loại kháng sinh hiện được kê đơn. Vi khuẩn đất tiết ra các hóa chất hoặc ức chế hay tiêu diệt vi khuẩn cạnh tranh, và chủng xạ khuẩn đặc biệt này đã gây rối với một số tác nhân mầm gây bệnh mà các loại kháng sinh hiện có không thể chọc thủng được.
Một trong những loại siêu vi khuẩn ngày càng phổ biến hiện nay là Tụ cầu vàng (Staphylococcus aureus hay còn được biết đến dưới cái tên là MRSA (Tụ cầu vàng kháng methicillin)) vốn chịu trách nhiệm cho khoảng 1/3 số ca nhiễm “vi khuẩn ăn thịt người” ở Mỹ.
Đó là phát hiện ngẫu nhiên ra Penicillin của ông Alexander Fleming vào năm 1928: nấm mốc vô tình làm ô nhiễm đĩa Petri (đĩa thủy tinh dạng hình trụ có nắp đậy) tại phòng thí nghiệm của ông ở Bệnh viện St. Marys (London) và một số vi khuẩn xạ khuẩn mà từ đó đã hình thành một cách điều trị chữa nhiều chứng bệnh nhiễm trùng làm chết người.
Song bất chấp sự thành công của các liệu pháp đương thời thì các loại siêu vi khuẩn vẫn không ngừng phát triển ra các biến thể mạnh hơn và độc hại hơn. Siêu vi khuẩn đang được xem là mối đe dọa lớn nhất và khó hiểu nhất của mối đe dọa toàn cầu. Theo một báo cáo mới của Liên Hiệp Quốc (UN) thì các chứng nhiễm kháng kháng sinh đã tước đoạt mạng sống của ít nhất 70 vạn người mỗi năm (bao gồm 230.000 trường hợp chết chỉ riêng do bệnh lao kháng thuốc).
Theo UN, đến năm 2050, số người chết sẽ tăng lên đáng kể là 10 triệu người chết mỗi năm. Ngoài ra việc giảm hoặc lạm dụng dùng kháng sinh đã đóng góp vào đà trỗi dậy của vi khuẩn kháng kháng sinh. Mặt khác, phần lớn các loại thuốc kháng khuẩn đang sử dụng ngày hôm nay chỉ là việc sửa đổi những loại thuốc đã tồn tại hơn nửa thế kỷ.
Trong hành trình tìm ra thuốc đặc trị vi khuẩn, các nhà nghiên cứu đang để mắt tới việc điều tra vào những thảo dược cổ xưa, các kỹ thuật chữa bệnh và y học dân gian. Đó cũng là đề tài nghiên cứu của ông Gerry Quinn tại nghĩa địa của Nhà thờ Công giáo La Mã Thánh Tâm.
Bằng chứng khoa học
Kiến thức dân gian về loại đất sét độc đáo Boho đã có từ người Druids huyền bí (những người đã ngụ cư ở đây từ 1.500 năm trước và có lẽ trải dài sang thời đại Đồ Đá Mới từ 3.500 năm trước).
![]() |
| Tại phòng thí nghiệm ở Đại học Swansea (Wales, Anh), ông Paul Dyson cầm cái đĩa nuôi xạ khuẩn. Ảnh nguồn: Jason Pietra. |
Dessie McKenzie, ông chủ của Linnet Inn (quán rượu duy nhất ở Boho) cho biết: “Mỗi thành phố và làng mạc ở Ireland dường như đều có liên quan đến một cách chữa bệnh lấy từ ai đó và trả lại. Chúng là những bí mật ẩn giấu trong thần thoại Ireland”. Gerry Quinn nghe câu chuyện về đất chữa bệnh từ huyệt mộ của Cha McGirr từ người bác của mình với lời cam đoan rằng nó có thể chữa được căn bệnh vàng da.
Nhà vi trùng học Gerry Quinn dẫn giải: “Vào những ngày trước khi ra đời kháng sinh, chữa bệnh còn là một sự kiện tâm linh. Người khỏe mạnh ở vùng nông thôn bỗng lăn đùng ra ốm và không khỏe lại. Bất kỳ ai khỏi bệnh cũng được cho là do phép màu, vì lẽ đó mà không hề ngạc nhiên khi có quan hệ đan xen giữa tôn giáo và nghệ thuật chữa bệnh”.
Dần dà người dân tìm thuốc chữa bệnh không phải vì “sự màu nhiệm” của Cha McGirr mà là thông qua một số điều tra khoa học. Ông Quinn đã khởi động chương trình nghiên cứu của mình tại Đại học Swansea nơi ông là nghiên cứu sinh Tiến sĩ.
Ông Paul Dyson, một nhà vi trùng học phân tử, người đứng đầu nhóm nghiên cứu về Vi khuẩn phân tử ứng dụng (AMM) tại Swansea, ông cũng tiến hành các nghiên cứu về cô lập khuẩn xạ khuẩn trực tiếp từ các môi trường khô hạn bao gồm cao nguyên Tây Tạng và các đồn điền cây chà là ở Arab Saudi.
Ông Paul Dyson giải thích: “Mỗi diện tích nhỏ môi trường đều có một cộng đồng vi sinh vật khác nhau. Lý do để xạ khuẩn tạo ra kháng sinh là vì không như phần lớn vi khuẩn khác, chúng là bất động hay là những sinh vật thụ động. Và để bảo vệ môi trường vi mô của mình, chúng sẽ tự sản xuất kháng sinh để tiêu diệt các sinh vật cạnh tranh vào vùng lân cận với chúng”.
Mới trở về từ miền Bắc Trung Quốc, ông Paul Dyson hy vọng sẽ tìm thấy một số loài xạ khuẩn mới mẻ từ những vùng đất khắc nghiệt trên đất nước này. Ông Gerry Quinn cũng cố gắng thực hiện các thử thách để vi khuẩn có thể sống sót trong phòng thí nghiệm, ông phát biểu: “Ban ngày, tôi để vi khuẩn trong lồng ấp ở nhiệt độ 1130C; ban đêm nhiệt độ tụt xuống 390C. Trong thời gian đó, xạ khuẩn đã phát triển mạnh. Thí nghiệm đã khiến ông Quinn nghĩ đến loại đất bí mật ở Boho.
Ông Quinn biết rằng xạ khuẩn có thể sống ở các hồ nước kiềm hay hang động, và khu vực Boho là một trong số những đồng cỏ chứa kiềm ở Bắc Ireland. Trong lần về thăm người dì, ông Quinn đề nghị muốn thử nghiệm một số loại đất sét và nghĩ tới ngôi mộ của Cha McGirr. Nghĩ là làm, ông Quinn đã lấy một số mẫu đất để mang về Đại học Swansea nghiên cứu. Trong phòng thí nghiệm của mình, Quinn đã dùng một giao thức đặc biệt để phân lập 8 chủng xạ khuẩn từ đất Boho.
Ông Luciana Terra (một thành viên nghiên cứu đến từ Brazil) đã đưa xạ khuẩn chống lại các mầm bệnh phổ biến. Cuối cùng, bộ gene đã được giải trình tự bằng cách nuôi mỗi cá thể vi khuẩn trên một đĩa nuôi riêng biệt, trích xuất ADN và đọc các mảnh ADN trong trình tự sắp xếp và so sánh trình tự này với các chủng xạ khuẩn đã được biết tới. Các chủng xạ khuẩn mới sẽ được kết hợp với các loại siêu vi khuẩn.
Trước sự kinh ngạc của nhóm nghiên cứu, chủng xạ khuẩn mới đã ức chế cả trực khuẩn gram dương và gram âm, nhìn chung thì gram âm có khả năng kháng kháng sinh cao hơn do bởi độ dày tương đối từ thành tế bào của chúng.
Thế còn vi khuẩn mới nên gọi là gì? Một người bạn của ông Quinn đã gợi ý đặt tên cho chủng xạ khuẩn mới là Myrophorea (cái tên này lấy từ tiếng Hy Lạp dùng để nói những phụ nữ mang nhựa cây Một Dược theo kinh Tân ước). Sau khi ông Luciana Terra xử lý các mẫu đất, ông Quinn liền quay trở lại Boho để chôn đất xuống mộ Cha McGirr.
Quyền năng trị bệnh của đất sét
Đang có tình trạng hỗn loạn trong mô hình phát triển kháng sinh hiện tại. Do lợi nhuận ít ỏi và các rào cản pháp lý nên các hãng dược phẩm đã từ bỏ nghiên cứu trong lĩnh vực này. Để đưa một loại thuốc mới ra thị trường cũng đòi hỏi khá lâu thời gian (từ 10 đến 15 năm) và tiền bạc (có thể lên tới 2 tỷ USD).
Không giống như thuốc điều trị các bệnh mãn tính như ung thư hay tiểu đường, phần lớn các loại kháng sinh được sử dụng trong thời gian tương đối ngắn và bệnh thường được chữa khỏi. Dù giá cao vẫn không thành vấn đề, song các loại thuốc mới vẫn giữ hồ sơ thấp trong thế giới phát triển và đang phát triển, không khuyến khích các hãng dược phẩm mở thêm các đại lý mới.
Năm ngoái 2018, 3 ông trùm dược phẩm thế giới (Merck, Pfizer và GlaxoSmithKline) đã đóng cửa các chương trình kháng sinh của họ. Cho rằng vi khuẩn có thể nhanh chóng phát triển ra khả năng kháng với một loại kháng sinh mới, các chuyên gia y tế công cộng đã khuyên bác sĩ nên kê đơn chúng càng ít càng tốt.
Và đó cũng là lý do để cả ông Paul Dyson và Gerry Quinn cùng hy vọng sẽ tiếp tục nghiên cứu của họ trong tương lai với nguồn ngân sách từ các tổ chức phi lợi nhuận cũng như không phải đối mặt với áp lực tạo ra thu nhập.
Đối với ông Julian Davies, để nhận được sự hỗ trợ tài chính cũng khó y chang như nắm bắt con vi khuẩn vốn rất trơn tuột. Ông Davies, một nhà vi trùng học người Anh, đã làm cố vấn cho ông Paul Dyson tại Viện Pasteur (Paris) và dẫn đầu một nhóm Canada đã khám phá ra một hoạt động kháng vi khuẩn tiềm tàng trong một mỏ đất sét băng hà ở ngoài khơi vịnh Kisameet (British Columbia).
Loại đất sét mịn có màu xanh lá cây nhạt đã được nhiều thế hệ người bản địa Tiểu quốc Heiltsuk sử dụng nhằm đặc trị bỏng, tiểu đường, viêm và bệnh vẩy nến. Năm 2011, Heiltsuk đã cho phép một công ty được quyền khai thác đất sét mà thương hiệu hiện tại là Kisolite.
Ông Davies được hãng Đất sét băng hà Kisameet (KGC) thuê để nghiên cứu về các đặc tính kháng khuẩn của đất sét. Trong phòng thí nghiệm của mình, ông Davies và các đồng nghiệp đã phát triển ra một chiết xuất cực mạnh để quét sạch 16 chủng vi khuẩn được thử nghiệm bao gồm cả các siêu vi khuẩn. Ông Davies bật mí rằng đất sét cũng có khả năng tiêu trừ chứng loét Mycobacterium gây suy nhược nhiễm trùng da.
Thế rồi KGC ngừng tài trợ cho nghiên cứu của ông Davies, có vẻ như chỉ nhắm vào khai thác đất sét cho nhu cầu sản xuất mỹ phẩm.
Lại nói về cao nguyên Boho. Tin tức về việc khám phá ra khả năng kháng khuẩn trong mộ huyệt của Cha McGirr đã làm kích thích một dòng hành hương bất tận của nhiều tín đồ đổ về Nhà thờ Thánh Tâm. Về thứ đất mộ chữa bệnh, Dessie McKenzie, một người dân Ireland hiếu khách, khẳng định: “À, ở đây cư dân đều tin rằng đất không phải là đồ bẩn, mà nó là thứ tiềm ẩn sức mạnh khó giải thích”.